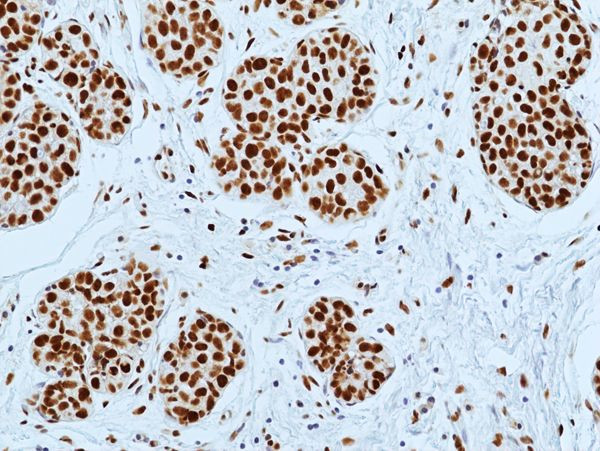
DNA-PK Antibody in Immunohistochemistry (Paraffin) (IHC (P))

Search
Invitrogen
DNA-PK Recombinant Rabbit Monoclonal Antibody (RM505)
{{$productOrderCtrl.translations['antibody.pdp.commerceCard.promotion.promotions']}}
{{$productOrderCtrl.translations['antibody.pdp.commerceCard.promotion.viewpromo']}}
{{$productOrderCtrl.translations['antibody.pdp.commerceCard.promotion.promocode']}}: {{promo.promoCode}} {{promo.promoTitle}} {{promo.promoDescription}}. {{$productOrderCtrl.translations['antibody.pdp.commerceCard.promotion.learnmore']}}
产品信息
MA562148
种属反应
宿主/亚型
Expression System
分类
类型
克隆号
抗原
偶联物
形式
浓度
纯化类型
保存液
内含物
保存条件
运输条件
RRID
产品详细信息
This antibody reacts to human DNA-PKs (DNA-PK catalytic subunit).
靶标信息
DNA-PK is a heterotrimeric, DNA-dependent protein kinase that initiates signaling cascades in response to DNA damage. DNA-PK is an atypical kinase, closely related to the PI3 kinases, and is often potently inhibited by small molecules designed to target PI3 kinases. DNA-PK encodes a component of the mediator complex, a transcriptional coactivator complex thought to be required for the expression of almost all genes. The mediator complex is recruited by transcriptional activators or nuclear receptors to induce gene expression, possibly by interacting with RNA polymerase II and promoting the formation of a transcriptional pre-initiation complex. Multiple transcript variants encoding different isoforms have been found for DNA-PK.
仅用于科研。不用于诊断过程。未经明确授权不得转售。
篇参考文献 (0)
生物信息学
蛋白别名: DNA-activated protein kinase catalytic subunit; DNA-dependent protein kinase catalytic subunit; DNA-PK catalytic subunit; DNPK1; hyper-radiosensitivity of murine scid mutation, complementing 1; p460; protein kinase, DNA-activated, catalytic polypeptide; S473K; Ser-473 kinase; unnamed protein product
基因别名: DNA-PKC; DNA-PKcs; DNAPK; DNAPKc; DNPK1; HYRC; HYRC1; IMD26; p350; PRKDC; S473K; XRCC7
UniProt ID: (Human) P78527
Entrez Gene ID: (Human) 5591